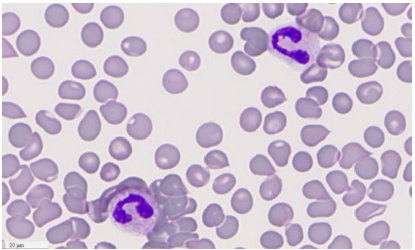
O8 Microscope and Scanner – Fully digital and motorized all-in one microscope and scanner, specifically optimised for oil scanning._2172979

The PreciPoint O8 Microscope and Scanner is a fully digital, motorized all-in-one solution specifically optimized for oil scanning. Combining precision optics with advanced scanning capabilities, it delivers fast, accurate imaging ideal for laboratories requiring high-quality oil analysis and digital documentation.
Product Features
- Five different scanning modes available for versatile imaging needs
- Fast scanning and snapshot creation within 60 seconds
- Supports slides of 26x76mm (2 slides), 51x76mm (1 slide), or any slide up to 51mm (W) × 76mm (L)
- Remote control capability via Team Viewer or associated platforms
- Auto focus for sharp, precise imaging
- Annotations, measurements, manual counting, and color tools integrated
- High positioning accuracy of x-y stage: ±4 μ + 0.3 · 10⁻³ · L
- Repeatability of x-y stage: 2 μ + 0.01% of travel range
- Compatible with Windows 7-10, USB 3.0 connectivity
- Required computer: Dell (as per quote) — optimized for high graphics and processing demands
- Weight: 25 kg
- Dimensions: 53.2 cm (H) × 29.5 cm (W) × 47.3 cm (D)
- Optional barcode recognition available (not included)
- 12 months warranty included
Applications And User Segments
- Designed specifically for oil scanning with 50x, 60x, and 100x objectives
- Air scanning capability from 10x to 100x magnification
- Suitable for a broad range of users including research labs, pharmaceutical companies, and quality control laboratories
- Supports building digital reference databases and remote routine testing and documentation
- PreciPoint technology ensures precision optics, optimized software, and tailored x-y stage for demanding imaging needs
- Helps laboratories achieve optimization goals with smart, reliable scanning solutions
Benefits
- High-speed scanning and snapshot capability saves valuable lab time
- Precision motorized x-y stage ensures accurate and repeatable imaging
- Remote control functionality enables flexible operation from desktop or mobile devices
- Versatile slide compatibility supports a wide range of sample formats
- Integrated annotation and measurement tools enhance data analysis and reporting
- Optimized hardware and software ensure superior image quality and reliability
- Compact, all-in-one design saves bench space without compromising performance
Why Choose the PreciPoint O8 Microscope and Scanner?
The PP Systems O8 Microscope and Scanner offers an unparalleled combination of speed, precision, and versatility tailored specifically for oil scanning applications. Its advanced motorized system, high-resolution optics, and innovative PreciPoint technology make it an ideal choice for research institutions, pharmaceutical labs, and industrial facilities. With remote operation capabilities and comprehensive software tools, the O8 empowers users to conduct detailed imaging and analysis efficiently and accurately. Backed by a 12-month warranty and designed for demanding environments, the O8 is a smart investment for labs seeking cutting-edge microscopy solutions.